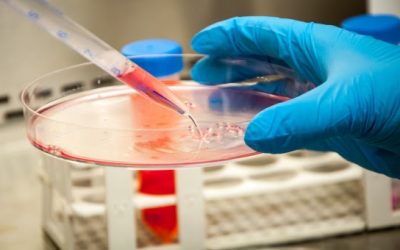
Construyen una biblioteca de nanoanticuerpos de llamas contra la COVID-19

Coronavirus en Argentina: confirmaron 264 nuevas muertes y 11.674 casos en las últimas 24 horas
El total de infectados en todo el país asciende a 589.012 y las víctimas fatales suman 12.116. En tanto, un total de 3.049 personas cursan la enfermedad en unidades de terapia intensiva.
Coronavirus en Argentina: confirmaron 185 muertes y 11.892 contagiados en las últimas 24 horas
El total de infectados en todo el país asciende a 577.338 y las víctimas fatales suman 11.852. Un total de 2.982 personas cursan la enfermedad en unidades de terapia intensiva.
Construyen una biblioteca de nanoanticuerpos de llamas contra la COVID-19
Se trata del primer reservorio elaborado en la Argentina y que contiene información sobre los anticuerpos que producen estos camélidos frente al SARS-CoV-2.
Coronavirus en Argentina: confirmaron 315 muertes y 9.909 nuevos contagios en las últimas 24 horas
El Ministerio de Salud informó que el total de casos, desde que comenzó la pandemia, ascendió a 565.446 y que los fallecidos suman 11.667
El Experimento Minnesota y el por qué NO a las dietas mágicas
Argentina es uno de los países que con más “dietas y recursos para bajar muchos kilos en 10 días”, tenemos dietas de 700 kcal diarias, batidos de diversos sabores, dieta paleo, la cetogénica, panqueques en polvo, viandas, jugos adelgazantes, celebrities recomendando píldoras, fanáticos por el ayuno intermitente y los instagramers dando consejos sin aval profesional.
Coronavirus en Argentina: confirmaron 89 muertes y 9.056 nuevos contagios en las últimas 24 horas
El total de infectados en todo el país asciende 555.537 y las víctimas fatales suman 11.352.
Coronavirus en Argentina: confirmaron 115 muertes y 10.776 nuevos contagios en las últimas 24 horas
El total de infectados en todo el país asciende a 546.481 y las víctimas fatales suman 11.263. Un total de 3.093 personas cursan la enfermedad en unidades de terapia intensiva.
Coronavirus en Argentina: confirmaron 250 muertes y 11.905 nuevos contagios en las últimas 24 horas
El total de infectados en todo el país asciende a 524.198 y las víctimas fatales suman 10.907.
Nuevo récord: confirmaron 254 nuevas muertes por coronavirus y 12.259 casos en las últimas 24 horas
El total de infectados en todo el país asciende a 512.293 y las víctimas fatales suman 10.658. Un total de 2.719 personas cursan la enfermedad en unidades de terapia intensiva en todo el país
Coronavirus en Argentina: confirmaron 278 muertes y 12.027 nuevos contagios en las últimas 24 horas
A pesar de los 171 días de cuarentena, el total de infectados en todo el país asciende a 500.034 y las víctimas fatales suman 10.405. Desde el Ministerio de Salud de la Nación indicaron que un total de 2.698 personas cursan la enfermedad en unidades de terapia intensiva en todo el país.
Coronavirus: tras 171 días de cuarentena, Argentina superó las 10.000 muertes
En las últimas 24 horas se registraron 271 nuevas víctimas fatales y 9.215 contagios. Tras casi seis meses de cuarentena, el total de infectados en todo el país asciende a 488.007 y las víctimas fatales suman 10.129.
Coronavirus en Argentina: confirmaron 120 nuevas muertes y 6.986 contagios en las últimas 24 horas
El total de infectados en todo el país asciende a 478.792 y las víctimas fatales suman 9.859. Con un promedio de 53 decesos por jornada desde el primer caso, el ritmo de nuevos fallecimientos diarios se duplicó en los últimos 20 días.
Coronavirus en Argentina: confirmaron 262 muertes y 10.684 contagiados en las últimas 24 horas
El total de infectados en todo el país asciende a 461.882 y las víctimas fatales suman 9.623. De las cuales 2.359 personas permanecen internadas en unidades de terapia intensiva.
Récord: confirmaron 245 muertes y 12.026 nuevos contagios en las últimas 24 horas en Argentina
A pesar de los 167 días de cuarentena se registró el número más alto de contagios en una jornada. El total de infectados en todo el país asciende a 451.198 y las víctimas fatales suman 9.361.